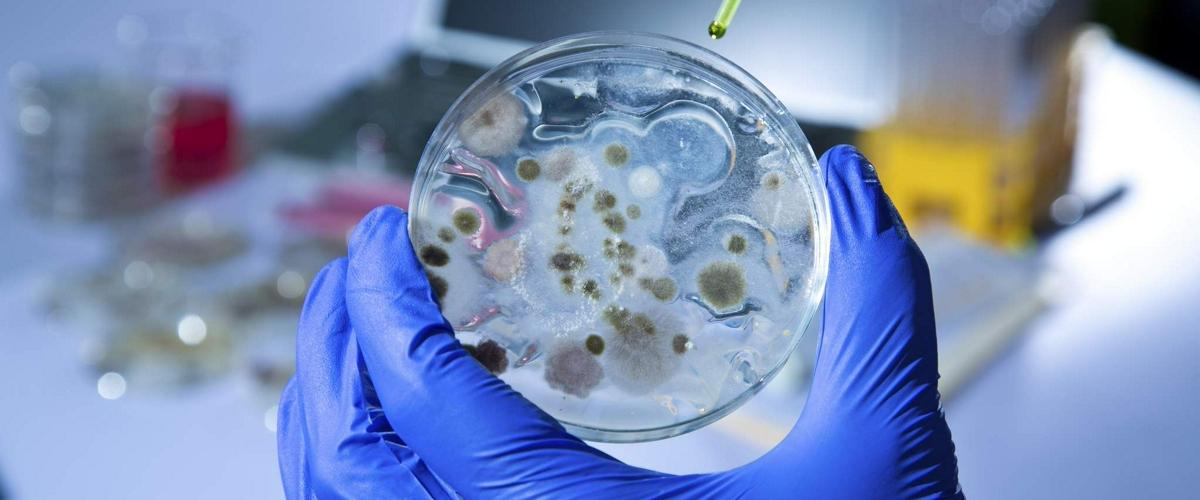

В 2009 году у пациента одной из японских клиник впервые было выявлено заболевание, вызванное грибком Candida auris. В течение последующих лет этот организм быстро распространился по другим странам, включая США. Инфекция проникает в организм пациентов с ослабленной иммунной системой и убивает от 30 до 60% зараженных. При этом некоторые штаммы выработали устойчивость ко всем известным противогрибковым препаратам.
Обычно высокая температура тела человека хорошо защищает его от большинства грибковых инфекций. Однако Candida auris каким-то образом удалось адаптироваться к высоким температурам.
Согласно исследованию американских ученых, стимулом для эволюции грибка стало глобальное потепление. Команда изучила температурные предпочтения Candida auris и нескольких десятков родственных видов. Исследователи провели ряд экспериментов, а также учли экспрессию генов и экологические особенности разных грибков.
Согласно полученным данным, в недавнем прошлом Candida auris был водным организмом, растущим на мертвой органике. Однако рост температуры воды направил его эволюцию на выработку устойчивости к высоким температурам, что позволило ему освоить новую экосистему — организм человека. Вероятно, некоторые необходимые для этого гены грибок получил от других видов за счет горизонтального переноса.
Ученые полагают, что Candida auris сначала заражал водоплавающих птиц, а затем через домашнюю птицу передался фермерам. Сегодня главным источником опасной инфекции считаются больницы.
По мере того, как планета продолжает нагреваться, Candida auris совершенствует свои адаптации к горячей солоноватой воде. Это значит, что в ближайшем будущем теплокровность человека окончательно перестанет сдерживать эту смертельно опасную инфекцию.
По мнению немецких исследователей, в распространении устойчивых к антибиотикам бактерий также может быть повинно глобальное потепление. Они обнаружили связь между резистентностью отдельных возбудителей и средней температурой теплого сезона.